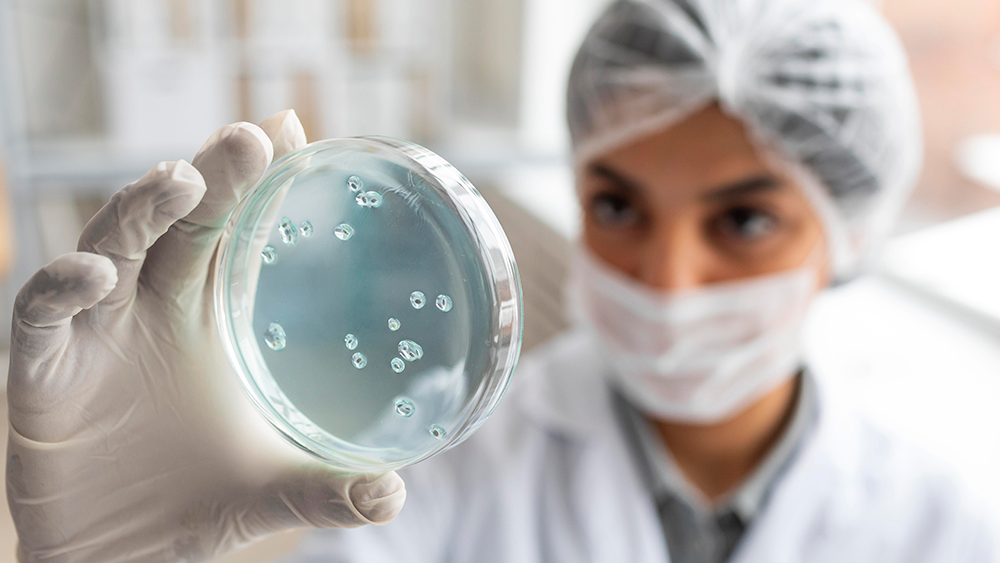

O impacto do estresse nas funções urinárias e sexuais, e como cuidar disso em 2026
O estresse é um fator silencioso que pode afetar profundamente a saúde masculina, incluindo funções

O estresse é um fator silencioso que pode afetar profundamente a saúde masculina, incluindo funções

O Novembro Azul é essencial para conscientizar sobre o câncer de próstata, mas os cuidados

O corpo humano é sábio e costuma enviar sinais quando algo não vai bem, mas

Muitos homens ainda deixam para procurar o urologista apenas quando sentem dor ou algum sintoma

Uma alimentação equilibrada não serve apenas para manter o peso ideal ou prevenir doenças cardíacas,

O Prêmio Nobel de Medicina de 2025 foi concedido a Mary E. Brunkow, Fred Ramsdell

A saúde intestinal vai muito além de apenas “não estar com dor de barriga”. Ela
Pesquisadores dos Estados Unidos anunciaram um marco impressionante na biologia reprodutiva: pela primeira vez, células

O câncer de próstata é o segundo tipo de câncer mais comum entre os homens

Cuidar da saúde vai muito além de tratar doenças quando elas já aparecem. O verdadeiro
Tenha um atendimento de excelência no cuidado urológico e saúde do homem com o Manoel Guimarães, onde cada consulta é única e personalizada para atender às suas necessidades.
O site utiliza cookies e outras tecnologias para melhorar a sua experiência. Ao continuar navegando, você concorda com a utilização dessas tecnologias, como também, concorda com os termos da nossa política de privacidade.